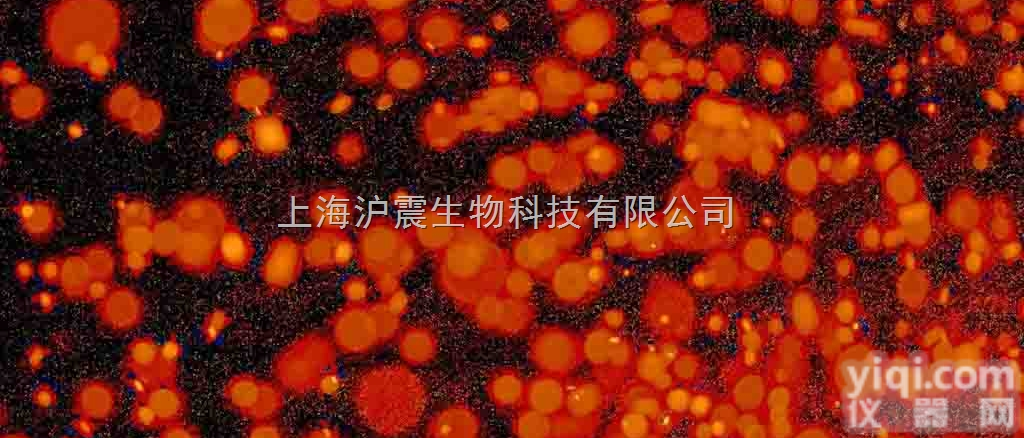
<em>小鼠</em>肾足<em>细胞</em> Mouse <em>podocyte</em><em>细胞</em>

公司是Z专业的ATCC细胞供应商,提供小鼠肾足细胞,Mouse podocyte细胞的报价,小鼠肾足细胞,Mouse podocyte细胞咨询,技术服务,欢迎来电咨询选购。
产品名称:小鼠肾足细胞,Mouse podocyte细胞
Mousepodocytecell,Mousepodocyte
规格:5×105cells/瓶
型号:FS-1426
作用:科研使用,不可应用于ZL等其他方面
保存条件:4℃保存一年;-20℃长期保存
储存:液氮。
小鼠肾足细胞,Mouse podocyte细胞冷冻保存方法一:冷冻管置于4℃300分钟→(-20℃30分钟*)→-80℃16~18小时(或隔夜)→液氮槽长期储存。
冷冻保存方法二:冷冻管置于已设定程序之可程序降温机中每分钟降1-3℃至–80℃以下,再放入液氮槽期储存。-20℃不可超过1小时,以防止冰晶过大,造成细胞大量死亡,也可跳过此步骤直接放入-80℃冰箱中,但存活率稍微降低一些。
小鼠肾足细胞,Mouse podocyte细胞分裂图展示图:

购买小鼠肾足细胞,Mouse podocyte细胞注意事项:
1. 收到细胞后首先观察细胞瓶是否完好,培养液是否有漏液、浑浊等现象,若有上述现象发生请及时和我们联系。
2. 仔细阅读细胞说明书,了解细胞相关信息,如细胞形态、所用培养基、血清比例、所需细胞因子等。
3. 用75%酒精擦拭细胞瓶表面,显微镜下观察细胞状态。因运输问题贴壁细胞会有少量从瓶壁脱落,将细胞置于培养箱内静置培养过夜,隔天再取出观察。此时多数细胞均会贴壁,若细胞仍不能贴壁请用台盼蓝染色测定细胞活力,如果证实细胞活力正常,请将细胞离心后用新鲜培养基再次贴壁培养;如果染色结果显示细胞无活力,请拍下照片及时和我们联系,信息确认后我们为您再免费寄送一次。
4. 请客户用相同条件的培养基用于细胞培养。培养瓶内多余的培养基可收集备用,细胞传代时可以一定比例和客户自备的培养基混合,使细胞逐渐适应培养条件;建议直接购买提供的完全培养基。
5. 建议客户收到细胞后前3天各拍几张细胞照片,记录细胞状态,便于和技术部沟通交流。
6. 该细胞只能用于科研,不得用于临床应用。
CM-H108人表皮黑色素细胞完全培养基100mL
CM-H100胎儿表皮角化细胞完全培养基100mL
CM-H092人脉络膜血管细胞完全培养基100mL
CM-H084人脐静脉平滑肌细胞完全培养基100mL
CM-H076人心房肌细胞完全培养基100mL
CM-H068人膀胱上皮细胞完全培养基100mL
CM-H060人睾丸支持细胞完全培养基100mL
CM-H052人胎盘绒毛膜细胞完全培养基100mL
CM-H044人肝动脉内皮细胞完全培养基100mL
CM-H036人小肠平滑肌细胞完全培养基100mL
CM-H028人淋巴血管内皮细胞完全培养基100mL
CM-H020人胰岛β细胞完全培养基100mL
CM-H027人淋巴成纤维细胞完全培养基100mL
小鼠肾足细胞,Mouse podocyte细胞用于酸性缺罐头食品商业无菌检验(GB标准)酸性肉汤Rat Matrix metalloproteinase-3—MMP-3 ELISA kit 大鼠基质金属蛋白酶3(MMP-3)ELISA kit 规格: 96T/48TAcid Broth250
用于婴儿食品和乳粉中泛酸测定泛酸测定培养基Rat Matrix metalloproteinase-7—MMP-7 ELISA kit 大鼠基质金属蛋白酶7(MMP-7) 规格: 96T/48TPantothenic Acid Assay Medium250
用于婴儿食品和乳粉中游离生物素测定游离生物素测定培养基Rat Matrix metalloproteinase-8—MMP-8 ELISA kit 大鼠基质金属蛋白酶8(MMP-8) 规格: 96T/48TFree Biotin Assay Medium250
肠杆菌科细菌的生化试验三糖铁培养基Rat MBP ELISA Kit 大鼠髓磷脂碱蛋白(MBP) 规格: 96T/48TTriple Sugar Iron Agar250克
大肠埃希氏菌快速荧光测定MUG培养基Rat MBP ELISA Kit 大鼠髓磷脂碱蛋白(MBP) 规格: 96T/48TMUG-Medium(with Kovacs)培养基20g+靛基质20m
沙门氏菌属和志贺氏菌属的分离培养SS琼脂Rat MD2 ELISA Kit 大鼠髓样分化蛋白-2(MD2) 规格: 96T/48TSalmonella Shigella Agar250克
用于培养支原体的基础培养基支原体培养基基础Rat Methylase ELISA Kit 大鼠甲基化酶(Methylase) 规格: 96T/48TMycoplasma Broth Base250
每支添加剂加入100ml气单胞菌培养基基础气单胞菌培养基添加剂Rat Methylase ELISA Kit 大鼠甲基化酶(Methylase) 规格: 96T/48TAmpicillin Selective Supplement10支
用于一次性使用卫生用品中溶血性链球菌的检验匹克氏肉汤基础B Rat MGα1 ELISA Kit 大鼠α1微球蛋白(MGα1) 规格: 96T/48TPick’s Broth Base B250
用于牛奶和乳制品中乳酸菌检测和分离培养(Merck方法)M17琼脂Rat MGβ2 ELISA Kit 大鼠β2微球蛋白(MGβ2) 规格: 96T/48TM17 Agar250
沙门氏菌分离培养BGS琼脂Rat microalbunminuria ELISA KIT 大鼠微量白蛋白尿(ALB) 规格: 96T/48TBGS Agar250克